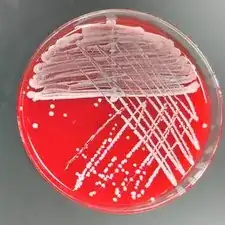
Block Image

Hello there! My name is Al Moran. I am a junior at the University of Wisconsin-Eau Claire with a major in Biology and a minor in Chemistry. I am super interested in science, specifically anatomy and physiology which I run study sessions for as a university employee. Someday I want to either go on to pharmacy school or become a college professor.
I currently work as a pharmacy technician, so I have a lot of experience adhering to safety protocols and dealing with insurance issues. I also work as a supplemental instruction leader for anatomy and physiology, so I have a lot of experience creating presentations/worksheets/activities and explaining difficult topics.
In my spare time, I love to read and be active, either at the gym or just going on a walk with my partner. I regularly rollerblade or bike to school and I enjoy hanging out and studying with my friends.
I anticipate this project won't have much to do with my future professional life, as I plan to work either directly with patients or with concepts. However, ifixit will definitely be useful in my personal life either as a resource at my disposal or as a motivation for conducting research that I can then share with others.
